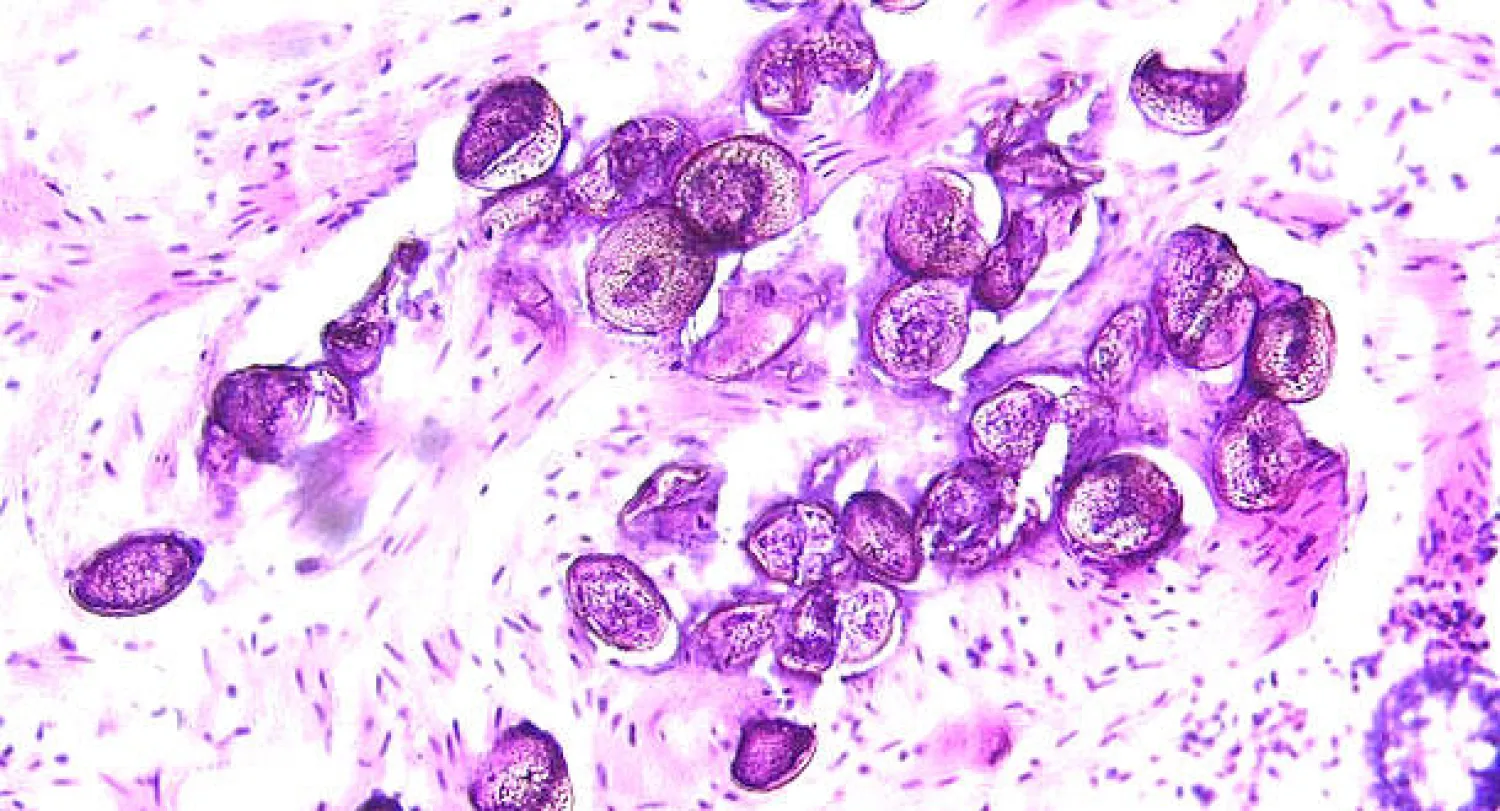
اكتشاف بويضة لطفيل البلهارسيا في سوريا عمرها 6200 سنة

قال علماء اليوم (الجمعة)، إن اكتشاف بويضة لطفيل البلهارسيا في مقبرة عمرها 6200 سنة في سوريا قد يمثل أقدم الشواهد على أن أساليب الري الزراعي في منطقة الشرق الأوسط كانت المسؤولة عن استشراء هذا المرض.
ويسبب داءَ البلهارسيا طفيلٌ ينتمي للديدان المفلطحة يعيش في الأوعية الدموية للعائل، بل أيضا المثانة والأمعاء. ويمكن أن تؤدي الإصابة بهذا المرض إلى فقر الدم «الانيميا» والفشل الكلوي وسرطان المثانة.
وفي دراسة أوردتها دورية لانسيت للأمراض المعدية قال الباحثون أن المرض قد يكون قد استفحل في أعقاب تطبيق نظام عتيق لري المحاصيل في حضارة بلاد الرافدين على ضفاف نهري دجلة والفرات وهي منطقة تشمل الآن أجزاء من العراق وإيران والكويت وسوريا وتركيا.
ومع مرور الزمن شاعت الإصابة بالبلهارسيا وصارت تمثل الآن عبئا ومرضا متوطنا في شتى أرجاء العالم. وتحدث الإصابة عندما يخترق الطفيل جلد العائل أثناء السباحة في مياه تعيش بها قواقع المياه العذبة التي تؤوي هذا الطفيل.
وتشير إحصاءات منظمة الصحة العالمية إلى أن نحو 240 مليون شخص يصابون بالبلهارسيا حول العالم فيما يعيش أكثر من 700 مليون شخص في مناطق يتوطن فيها المرض. وعثر على بيضة الطفيل في منطقة الحوض والمثانة والامعاء لرفات الشخص المصاب المدفون في جبانة.
وعثر فريق من علماء الاثار والسلالات البشرية على هذا الاكتشاف في منطقة تل زيدان بشمال سوريا. ويعمل هؤلاء الباحثون لدى جامعة كمبردج ومعهد قبرص ومعهد الدراسات الشرقية بجامعة شيكاغو بالولايات المتحدة.
وجمع الباحثون عينات من رفات الرأس والقدم بالمقبرة إضافة إلى عينات للمقارنة ووجدوا ان هذه العينات تحتوي على بيض الطفيل واشاروا إلى أن التلوث بالطفيل ليس حديث العهد.
وقال بيرز ميتشل من جامعة كمبردج البريطانية وهو المشرف عل هذه الدراسة ان هذه البويضة تمثل أقدم شاهد على ان قيام البشر بتطوير التقنيات في مجال الري على سبيل المثال تؤدي دون قصد منه إلى تفشي الأمراض.
وقال في بيان عن هذا الاكتشاف «الفرد الذي أصيب بالطفيل قد يكون قد استخدم أنظمة الري التي بدأ انتشارها انئذ في بلاد الرافدين منذ نحو 7500 عام».
وكانت أقدم بيضة لطفيل البلهارسيا قد اكتشفت في مومياء فرعونية مصرية عمرها 5200 سنة.
ويقضي طفيل البلهارسيا شطرا من دورة حياته في القواقع التي تعيش في المياه العذبة الدافئة قبل أن يجد طريقه إلى جسم العائل من خلال اختراق جلده أثناء السباحة أو الخوض في المياه الملوثة.
9:41 دقيقه
اكتشاف بويضة لطفيل البلهارسيا في سوريا عمرها 6200 سنة
https://aawsat.com/home/article/121551



اكتشاف بويضة لطفيل البلهارسيا في سوريا عمرها 6200 سنة


اكتشاف بويضة لطفيل البلهارسيا في سوريا عمرها 6200 سنة
لم تشترك بعد
انشئ حساباً خاصاً بك لتحصل على أخبار مخصصة لك ولتتمتع بخاصية حفظ المقالات وتتلقى نشراتنا البريدية المتنوعة











